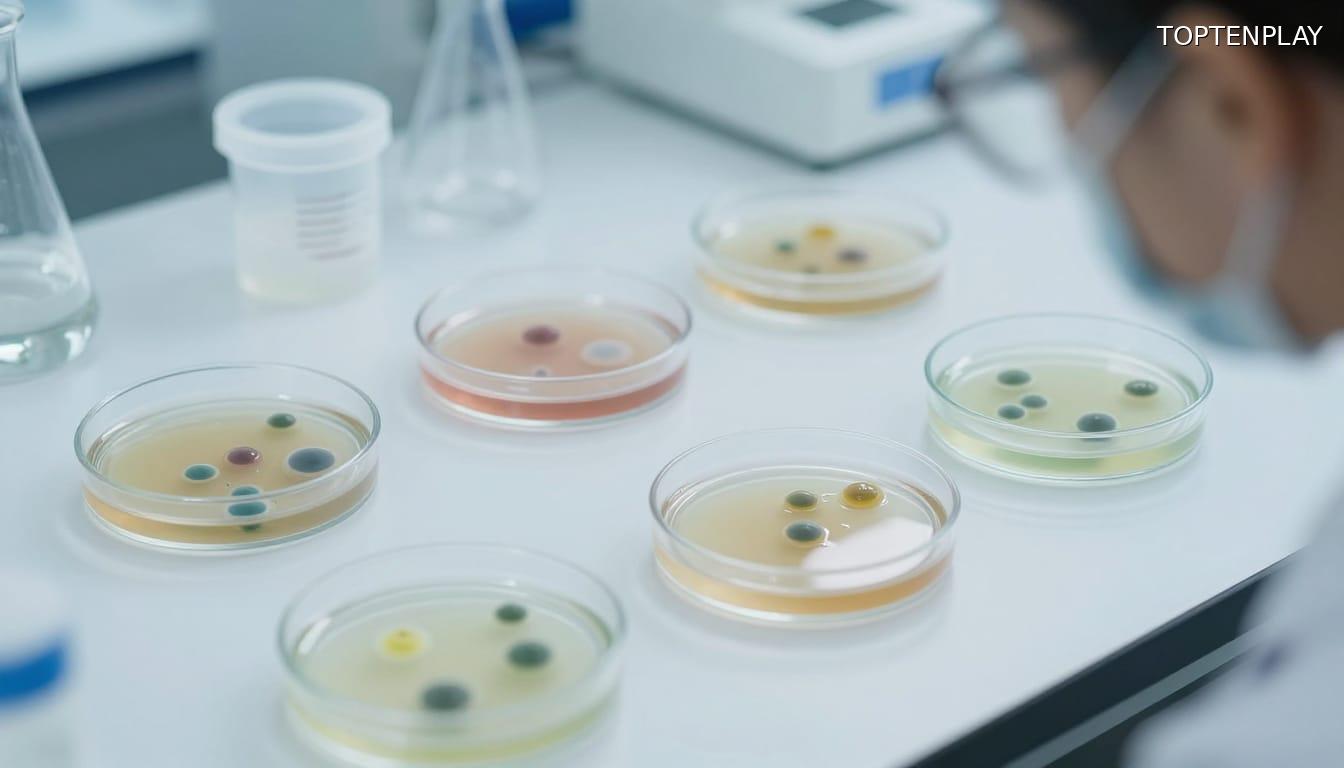
Image d'illustration © TopTenPlay

📌 Fromages Lait Bio du Maine : double contamination E. coli et Listeria détectée dans quatre variétés de gouda vendues en grande distribution

Posted 31 mars 2026 by: Admin

Alerte Sanitaire : Plusieurs Goudas Bio Retirés Des Rayons
Un rappel massif frappe plusieurs références de fromages gouda commercialisés par Lait Bio du Maine. Quatre variétés sont concernées : Gouda Le Vicoin, Gouda fenugrec, Gouda cumin et Gouda carré. Ces produits, distribués principalement en Mayenne via Super U Grand Ouest, Leclerc Socamaine, Carrefour Market et Carrefour Contact, ont également circulé à l’échelle nationale dans le réseau Biocoop et chez Biodis Prop à pro Team Ouest.
L’identification des lots s’avère délicate pour les consommateurs ayant acheté ces fromages au rayon à la coupe. Les références visées portent les codes GTIN 3760205423406, 3760205420511, 3760205420504 et 3760205420535. Tous les numéros de lot se terminant par 62 ou 621 sont concernés, avec des dates de limite de consommation s’échelonnant du 14 avril au 17 juillet 2026.
La procédure de rappel reste active jusqu’au 1er août 2026. Les analyses ont révélé une double contamination bactérienne susceptible de provoquer des intoxications alimentaires graves, particulièrement chez les personnes vulnérables. Même si le fromage présente un aspect normal, sa consommation expose à des risques sanitaires documentés.
Double Contamination Bactérienne Détectée
Les analyses microbiologiques ont révélé la présence d’Escherichia coli shiga toxinogène (STEC) et une suspicion de contamination par Listeria monocytogenes. Cette double menace pathogène distingue ce rappel des alertes sanitaires habituelles et justifie la rapidité de la procédure mise en œuvre par les autorités.
Listeria monocytogenes présente une particularité redoutable : son délai d’incubation peut atteindre huit semaines après l’ingestion du produit contaminé. La listériose se manifeste initialement par une fièvre accompagnée de courbatures et de maux de tête. Ces symptômes apparemment banals masquent un risque d’évolution vers des formes neurologiques sévères, notamment chez les populations fragiles.
L’infection à E.coli STEC suit un schéma clinique différent. Elle provoque des diarrhées parfois sanglantes, des douleurs abdominales intenses et des vomissements. Contrairement à la listériose, la fièvre n’accompagne pas systématiquement ces manifestations digestives. Les deux pathogènes partagent néanmoins une capacité à déclencher des complications graves nécessitant une hospitalisation.
La combinaison de ces deux agents bactériens dans un même lot de production soulève des questions sur les conditions de fabrication. Les protocoles sanitaires stricts imposés aux producteurs laitiers biologiques n’ont visiblement pas suffi à empêcher cette contamination croisée.

Populations À Risque Et Symptômes À Surveiller
Cette double contamination expose certains profils à des complications potentiellement mortelles. Les femmes enceintes figurent en première ligne : la listériose peut provoquer des avortements spontanés, des accouchements prématurés ou des infections néonatales graves. Le passage transplacentaire de la bactérie menace directement le fœtus, même lorsque la mère ne présente que des symptômes mineurs.
Les personnes âgées et les individus immunodéprimés complètent ce groupe vulnérable. Chez eux, Listeria monocytogenes franchit plus facilement la barrière hémato-encéphalique, déclenchant méningites et septicémies. Les chimiothérapies, greffes d’organes ou maladies chroniques affaiblissent les défenses naturelles qui contiennent habituellement ces pathogènes.
L’infection à E.coli STEC développe son propre tableau clinique alarmant. Les diarrhées sanglantes s’accompagnent de crampes abdominales violentes et de vomissements répétés. L’absence de fièvre trompe parfois les patients qui tardent à consulter. Pourtant, certaines souches produisent des toxines capables de détruire les globules rouges et d’endommager les reins, menant au syndrome hémolytique et urémique.
Toute personne ayant consommé ces goudas et développant ces manifestations doit consulter rapidement. Préciser au médecin l’exposition potentielle aux produits rappelés accélère le diagnostic et l’instauration d’un traitement adapté, réduisant ainsi les risques de séquelles durables.

Mode D’emploi Pour Les Consommateurs
Face à ces risques avérés, la marche à suivre ne souffre aucune approximation. Les fromages concernés doivent être détruits immédiatement, sans exception. La cuisson n’élimine pas les toxines produites par E.coli STEC, tandis que Listeria survit à des températures modérées. Toute consommation, même après passage au four, expose aux mêmes dangers.
L’interdiction s’étend au-delà du simple rejet. Ces goudas ne peuvent être donnés à des proches, cédés à des associations caritatives ou distribués à des animaux. La congélation pour un usage ultérieur reste proscrite : les bactéries entrent en dormance par le froid mais reprennent leur activité pathogène une fois le produit décongelé.
Pour identifier les lots contaminés, vérifiez les numéros GTIN : 3760205423406, 3760205420511, 3760205420504 et 3760205420535. Tous les lots se terminant par 62 ou 621 sont concernés, quelle que soit la date limite de consommation comprise entre le 14 avril et le 17 juillet 2026. Cette large fourchette temporelle explique la diffusion étendue des produits défectueux.
Le fabricant propose un dédommagement aux acheteurs lésés. Pour toute question sur la procédure de remboursement, contactez le 02 43 64 39 90 avant le 1er août 2026, date de clôture du dispositif. Conservez vos preuves d’achat pour faciliter le traitement de votre demande.




















